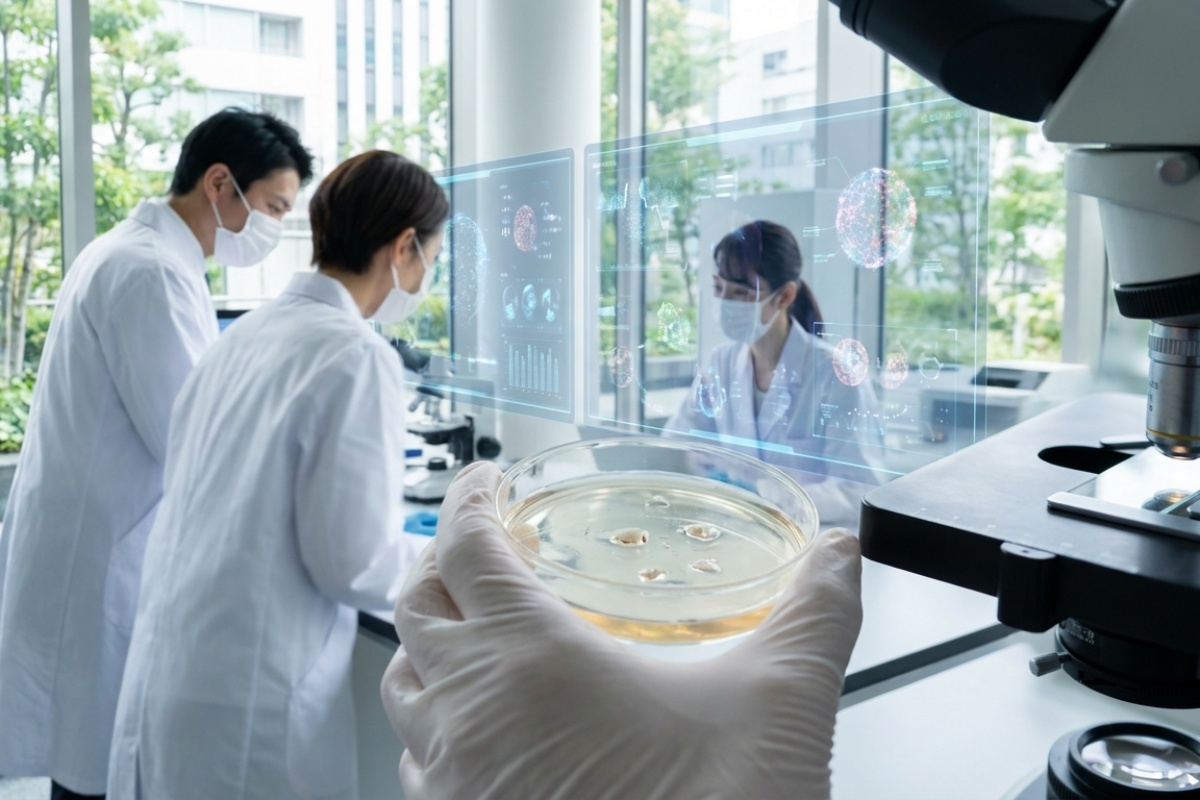
Japanski znanstvenici u žabama otkrili

Nevjerojatno otkriće u crijevima japanske žabe
Japanski istraživači došli su do fascinantnog otkrića koje bi moglo promijeniti modernu onkologiju. Bakterija Ewingella americana, izolirana iz crijeva japanske gorske žabe, pokazala je nevjerojatnu sposobnost u borbi protiv tumora.

Ova bakterija djeluje iznimno selektivno: ona se aktivira i razmnožava isključivo u okruženjima s vrlo niskim udjelom kisika, što je karakteristično za unutrašnjost kancerogenih tumora. Jednom kada se tamo nastani, ona učinkovito potiče imunološki sustav da prepozna i uništi stanice raka.
Rezultati koji obećavaju
Tijekom istraživanja, ovaj je pristup pokazao sljedeće prednosti:
- Učinak je bio snažniji od standardnih terapija koje se trenutno koriste.
- Nuspojave su ostale na minimalnoj razini i bile su samo privremene.
Sljedeća faza istraživanja uključuje testiranje na različitim vrstama karcinoma, kombiniranje s drugim metodama liječenja te se očekuje početak kliničkih ispitivanja na ljudima.









